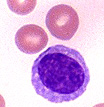

|
Cell Sim: The Worst Case |
Let's say
we wanted to create a complete portrait The CD-4
receptor of a T-Cell is the portal for all HIV infection, If a water
molecule were as wide as your thumb, If a water
molecule were as wide as a pixel, If
each screen was 1K by 1K pixels, That
is about the physical size of one IMAX screen, Assuming
a bulk discount of $200 per screen, Three dimensional
considerations complicate matters. That is a cube of processors about 5000 on a side. Assuming
a bulk discount of $10 dollars per CPU, Assuming
10 watts per CPU, So the Carlisle group would probably throw in the display for free. Upside,
many genetic and infectious diseases could be simulated and cured. Assuming
Moore’s law continues to hold true, I
think there are better ways to look at this, Cheers, - Van L. Van
Warren |
|